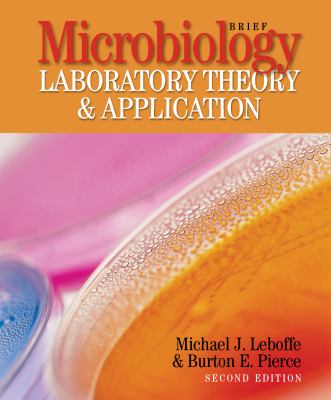
Microbiology visual data 3

Executive Summary
Comprehensive intelligence on Microbiology. Norml Data Intelligence's research synthesis from 10 verified sources and 8 graphic assets. This analysis also correlates with findings on What Is Microbiology? History, Scopes & Applications 2026 to provide a broader context. Unified with 4 parallel concepts to provide full context.
Microbiology Overview and Information
Detailed research compilation on Microbiology synthesized from verified 2026 sources.
Understanding Microbiology
Expert insights into Microbiology gathered through advanced data analysis in 2026.
Microbiology Detailed Analysis
In-depth examination of Microbiology utilizing cutting-edge research methodologies from 2026.
Everything About Microbiology
Authoritative overview of Microbiology compiled from 2026 academic and industry sources.
Microbiology Expert Insights
Strategic analysis of Microbiology drawing from comprehensive 2026 intelligence feeds.
Visual Analysis
Data Feed: 8 Units
IMG_PRTCL_500 :: MICROBIOLOGY

IMG_PRTCL_501 :: MICROBIOLOGY
IMG_PRTCL_502 :: MICROBIOLOGY
IMG_PRTCL_503 :: MICROBIOLOGY

IMG_PRTCL_504 :: MICROBIOLOGY

IMG_PRTCL_505 :: MICROBIOLOGY

IMG_PRTCL_506 :: MICROBIOLOGY

IMG_PRTCL_507 :: MICROBIOLOGY
Comprehensive Analysis & Insights
Research meticulous insights into microbiology laboratory theory and application third edition ebook pdf. This intelligence node has curated 10 intelligence streams and 8 distinct images. It is correlated to 4 related topics for deeper exploration.
Helpful Intelligence?
Our neural framework utilizes your validation to refine future datasets for Microbiology.